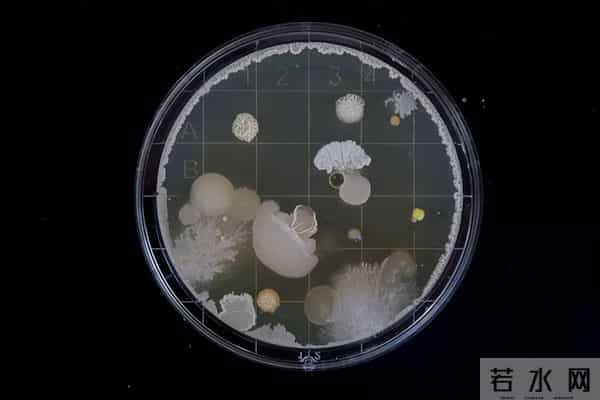
抗衰老新突破!干细胞外泌体调控衰老机制揭秘临床级产品标准落地

抗衰老新突破!干细胞外泌体调控衰老机制揭秘临床级产品标准落地
山东省齐鲁细胞治疗工程技术有限公司(以下简称“齐鲁细胞”)研发团队在干细胞抗衰领域取得的重要进展,或许能改变我们对调控细胞衰老的认知。

2025年10月26日,在国际医学期刊《World Journal of Stem Cells》上刊发了题为Efficacy of extracellular vesicles derived from mesen-chymal stromal cells in regulating senesce-nce: In vitro and in vivo insights的文章。由齐鲁细胞的研究者撰写的这篇论文揭示了脐带间充质干细胞来源外泌体(MSC-EVs)在调控细胞衰老中的作用,系统建立了符合cGMP标准的临床级外泌体制备流程,并明确了适用于人体应用的产品质量标准。团队通过体外细胞实验与D-半乳糖诱导的衰老小鼠模型,验证了MSC-EVs在减轻衰老相关标志物表达、改善组织病理变化、缓解氧化应激及调节代谢通路等方面的显著效果。
此前,人们已经认识到干细胞外泌体(exosomes)作为细胞间信息传递的“信使”所发挥的特殊功能。外泌体由干细胞分泌而来,其直径仅为30-150nm,然而它凭靠其富含的蛋白质、mRNA、microRNA等活性物质,可以促进促进胶原蛋白合成和血管新生,传递修复指令,这为医美领域(烧伤整形等)提供了极大的便利。并且,外泌体体积更小,可以自由穿越血脑屏障,研究者期望其在治疗阿尔茨海默症等神经系统疾病中发挥调控和抗炎作用。
此次齐鲁团队的研究内容还指出,来自间充质干细胞的外泌体可以降低衰老相关β-半乳糖苷酶活性及炎症因子表达,还能提升胶原蛋白合成,并在动物模型中明显改善肝脏组织结构与功能。

事实上,“抗衰”这一医疗愿景很难通过服药或摄入营养补剂等手段实现,它更接近于“全系统修复工程”。“衰老”往往涉及多组织器官的系统衰退,而干细胞疗法着眼于全面性、长期性,通过抑制慢性炎症、激活线粒体代谢、改善病灶部位的微循环、提高机体的细胞再生/替代实现“自我修复”,虽然缓慢温和,却坚定有效。
值得注意的是,齐鲁细胞研究团队针对干细胞外泌体的一系列研究还为干细胞及其衍生物的药物制备提供了理论指导。例如,在2023年11月3日,齐鲁细胞的研究人员在另一医学期刊《Stem Cell Reviews and Reports》中刊文,阐述了生产符合临床级、具有创面治疗效果的脐带间充质干细胞产品的质量控制策略,并回答了干细胞创面治疗中药物代谢、肿瘤安全性等一系列临床前研究问题。
齐鲁细胞的研究是为了实现cGMP标准的大规模干细胞研发、制备。这儿的cGMP标准是指符合动态药品生产管理规范(Current Good Manufacture Practices)。其核心在于通过规范生产现场操作和过程控制保障药品质量,需对生产偏差进行完整记录与调查。

为了使干细胞药物的生产流程符合规范,避免污染、混药,就需要对干细胞的提取培养、制备过程环境中实时的粒子、浮游菌和沉降菌等进行严密监控。一切有关质量控制环节的努力都是为了使临床应用的干细胞药物更为纯净,为干细胞在呼吸、生殖、血液、消化、神经以及皮肤疾病的治疗中发挥更稳定的作用。而齐鲁细胞的研究团队对干细胞外泌体降低衰老标志物表达、改善动物模型衰老病理的研究成果,将为干细胞抗衰治疗提供临床转化依据。
参考文献
[1
齐鲁细胞谭毅/杨双双团队发表外泌体抗衰老研究新成果
[2]刘晴晴,李可蕊,张嘉奕,等. 间充质干细胞外泌体在治疗衰老相关退行性疾病中的应用 [J/OL]. 生命科学, 1-24[2025-11-09].
[3]王婷,林福永,艾金伟,等. 间充质干细胞及其外泌体在医学美容领域的研究进展 [J]. 皮肤科学通报, 2024, 41 (05): 479-484.
[4]刘媛媛,张星月,张名望,等. 外泌体在皮肤抗衰及年轻化领域研究进展 [J]. 实用皮肤病学杂志, 2023, 16 (01): 33-37.
声明:本站所有文章资源内容,如无特殊说明或标注,均为采集网络资源。如若本站内容侵犯了原著者的合法权益,可联系本站删除。
